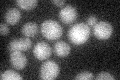
YGR150C
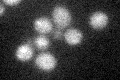
YGR150C

View description
Mitochondrial 15s rRNA-binding protein; required for intron removal of COB and COX1 pre-mRNAs; contains pentatricopeptide repeat (PPR) motifs; mutant is respiratory deficient and has defective plasma membrane electron transport
Localization:
Intensity:
Fold change:
Significance:
-
C’ GFP library in SD
below threshold16.37 -
N' NOP1pr-GFP in SD

bud50.521 -
N' TEF2pr-mCherry in SD

cell periphery,vacuole6.2433 -
N' NATIVEpr-GFP in SD

below threshold16.5187 -
N' TEF2pr-VC and Cyto-VN in SD

#N/A0 -
C’ GFP library in SD+DTT

cytosol18.581.13No -
C’ GFP library in SD+H2O2
cytosol17.471.06No -
C’ GFP library in Starvation Media

cytosol15.350.93No -
C’ GFP library on the background of Pup2-DaMP

below threshold -
C’ GFP library on the background of CCT mutant

below threshold16.80271.02608No
